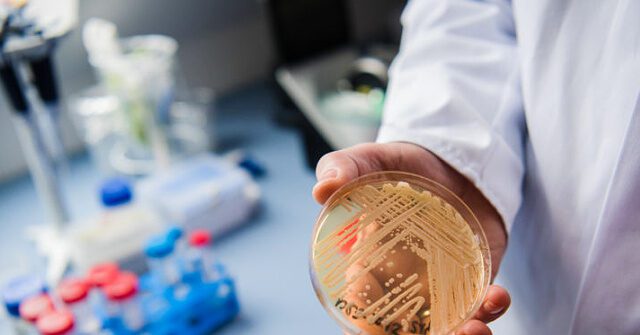

Fungal infection spread through sexual contact reported in Minnesota

Contagious Fungal Skin Infection Alert in Minnesota Minnesota health officials have issued a warning about an outbreak of a contagious fungal skin infection. This infection stems from Trichophyton genotype VII (TMVII), the same kind of fungus that causes ringworm. The primary symptom is a round, red, inflamed rash that can be itchy and painful, spreading […]
Twelve family members catch the fungal infection histoplasmosis after visiting a bat cave in Costa Rica.

A large family consisting of six adults and six children recently visited a bat cave in Costa Rica, but they came back with more than just souvenirs. The family, which spans three states—Georgia, Texas, and Washington—fell ill after their holiday. On January 17, 2025, the Centers for Disease Control and Prevention (CDC) reported several suspicious […]
New Fungal Infection Discovered In China Poses Threat To Humans

A new fungal infection called Rhodosporidiobolus fluvialis was recently discovered in two human patients in China, scientists revealed in June. The infection was discovered in samples from two separate hospital patients, according to a study published in the journal Nature Microbiology. R. fluvialis was resistant to a number of first-line antifungal medications such as fluconazole as […]
New, contagious fungal infection found in NYC — how to stay safe

In response to a new outbreak of a highly contagious fungal infection in New York City, health experts are sharing what you need to know to stay safe. An unidentified New York City man in his 30s First reported case in the United States Trichophyton mentagrophytes type VII (TMVII) is a rare sexually transmitted ringworm. […]
CDC Warns of Rapidly Spreading Fungal Infection with 60% Kill Rate
The Centers for Disease Control and Prevention (CDC) has issued a warning about a rapidly spreading fungal infection called Candida auris that has a 60% fatality rate. The first case of Candida auris infection was confirmed in Washington last month, and the infection has spread rapidly, mainly in medical facilities. The CDC warned that one […]
Michigan Chef Dies After Catching Deadly Fungal Infection That ‘Ate Holes In His Lungs,’ Family Says: REPORT

A Michigan chef has died after contracting a deadly fungal infection that affects his lungs, the Daily Mail reported Wednesday. Ian Pritchard, a 29-year-old chef from Petoskey, Michigan, died of a fungal infection after a long battle with life. according to to the Daily Mail. Pritchard, who is known for his cooking skills at local […]